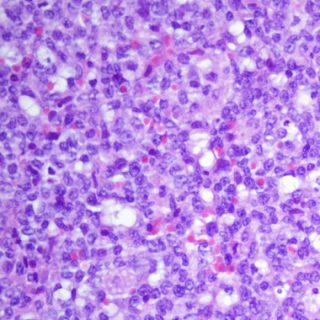

La comparación de este mapa de la leucemia con el de las células sanas revela cientos de regiones que cambian su funcionalidad con la enfermedad. Esto puede, por un lado, optimizar el conocimiento de la patología y, por otro, representar dianas potenciales para el desarrollo y aplicación de nuevas terapias.
Durante los últimos años, los estudios moleculares de la leucemia y de otros tipos de cáncer se han centrado en el análisis molecular de tan solo una capa de información, que proporcionaba una visión parcial y no permitía dibujar un mapa preciso de las funciones del genoma.
Este nuevo estudio ha dado un gran paso en la caracterización molecular completa de la enfermedad
“Este es un estudio sin precedentes en la investigación genómica del cáncer y subraya la importancia de integrar diferentes capas de información molecular para una mejor comprensión de la enfermedad”, explica Iñaki Martín-Subero, del Instituto de Investigaciones Biomédicas August Pi i Sunyer (IDIBAPS) y coordinador del estudio.
El mismo grupo de científicos que ha participado en este trabajo publicó, hace unos años, la secuencia del genoma y el metiloma de la leucemia. Este nuevo estudio ha dado un gran paso en la caracterización molecular completa de la enfermedad.
Utilizando técnicas de secuenciación de última generación y herramientas de biología computacional avanzadas, este trabajo proporciona un mapa detallado del funcionamiento del genoma de la leucemia.
Martín-Subero comenta que “conocer la secuencia del genoma no es suficiente para saber cómo funciona; para conocer sus funciones y su regulación es necesario el análisis integrador de múltiples capas epigenéticas”.
Iluminar las zonas oscuras del genoma
Uno de los mayores retos es el análisis computacional de datos masivos. Con la colaboración del Centro de Supercomputación de Barcelona, los investigadores han podido acceder a la alta capacidad de cálculo necesario para este complejo análisis.
Renée Beekman, primera firmante del trabajo afirma que, “el reto más importante al que nos enfrentamos una vez generados los datos era como analizar e integrar tantas capas de información, y destilar información que nos ayude a comprender mejor la leucemia. Han sido tres años de análisis informáticos para completar el mapa funcional de la leucemia”.
Los investigadores han podido identificar con precisión regiones con funciones específicas. En especial, las zonas oscuras del genoma –anteriormente llamadas ADN basura– se han iluminado, y en realidad contienen multitud de regiones esenciales para que el genoma funcione.
Según Martín-Subero, “hemos cartografiado por primera vez el mapa completo de las funciones del genoma de la leucemia, definiendo genes activos, genes inactivos, regiones que no contienen genes pero controlan su expresión, grandes desiertos inactivos del genoma… En total hemos identificado un total de 12 funciones diferentes”.
Tres proteínas, las responsables del cambio
Además de estudiar las células de la leucemia, los investigadores las han comparado con las células sanas. “Hemos observado cómo cambia el mapa de la leucemia en comparación con el mapa de las células sanas, y cómo las leucemias son capaces de crear una infraestructura molecular muy eficiente para crecer sin control”, subraya Beekman.
Además, los expertos descubrieron que tan solo tres familias de proteínas parecen estar encargadas de dicho cambio. Este es un aspecto importante ya que la acción de estas tres familias de proteínas puede ser inhibida con fármacos en desarrollo.
Elías Campo, director del equipo en el que trabajan Martín-Subero y Beekman, apunta que quizás este es el aspecto más significativo del estudio, “ya que ofrece una perspectiva terapéutica mediante la cual se puedan revertir las alteraciones funcionales en la leucemia”.
“Este mapa tan completo no solo nos permite comprender mejor la leucemia a escala molecular, sino que también ofrece una gran fuente de información para otros investigadores, con el fin conjunto de traducir los hallazgos en un mejor tratamiento y una mejor calidad de vida de los pacientes”, concluye Martín-Subero.
SINC


